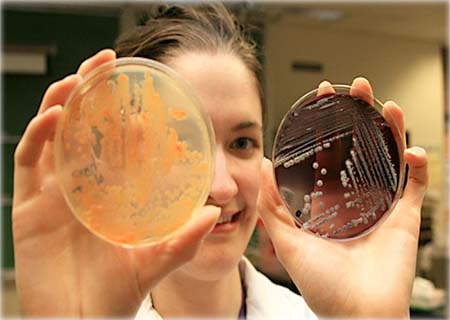

Remédio regenera tecidos danificados
Foto: thompsonrivers / Flickr
Um remédio experimental promete revolucionar a medicina regenerativa: a droga conseguiu reparar tecidos danificados do fígado, cólon e medula óssea em ratos de laboratório.
Caso a terapia funcione da mesma forma em seres humanos, pode vir a salvar vidas de muitas pessoas com doenças graves de cólon ou fígado, incluindo algumas formas de câncer.
O estudo, publicado na revista Science, foi conduzido por pesquisadores da Case Western Reserve e do Centro Médico UT Southwestern, nos Estados Unidos.
me
“Estamos muito animados”, afirmou Sanford Markowitz, professor de genética na Universidade de Medicina da Case Western Reserve e co-autor do estudo.
Até agora, o remédio é conhecido apenas como SW033291.
Ele pode “desligar” a actividade de um produto do gene que é encontrado em todos os humanos, a 15-hidroxiprostaglandina desidrogenase(15-PGDH).
Este, por sua vez, resulta na produção de mais prostaglandina E2, que estimula o crescimento e a reparação de diversos tipos de tecidos de células estaminais.
“O fármaco que desenvolvemos age como uma vitamina para as células estaminais de tecidos, estimulando a sua capacidade de reparar tecidos rapidamente”, acrescentou.
“O medicamento cura danos em muitos tecidos, o que sugere que poderia ser aplicado no tratamento de inúmeras doenças”, explicou Markowitz.
Mas os cientistas advertem que a pesquisa está ainda num estágio muito precoce e que mais testes são necessários, antes que possam ser feitas experiências em humanos.
Com informações do Zap.Aeiou
Matéria sugerida por Karen Gekker

México copia o SUS do Brasil e anuncia sistema de saúde gratuito para todos
Tratamento contra câncer de mama que não cai cabelo já está disponível no SUS
Médicos brasileiros fazem cirurgia inédita e salvam recém-nascida com problema congênito no coração
Remédio contra colesterol reduz risco de infarto em 30%, revela estudo
Vitamina B3 pode reverter gordura no fígado, descobrem cientistas
Primeiro porco clonado no Brasil nasce em SP e pode salvar milhares de vidas humanas
Coelhinho resgatado aprende a jogar Jenga e vira campeão; vídeo
Homem que vive na rua escreve bilhete pedindo ajuda para tratar cachorrinho doente… e consegue
Mulher “adota” idosa viúva que mudou de cidade sozinha: “anjos existem”
“Deus salvou a gente”, diz motorista de carro atingido por árvore durante tempestade
Menino de 8 anos comemora vitória contra o câncer dançando e dando pirueta; video